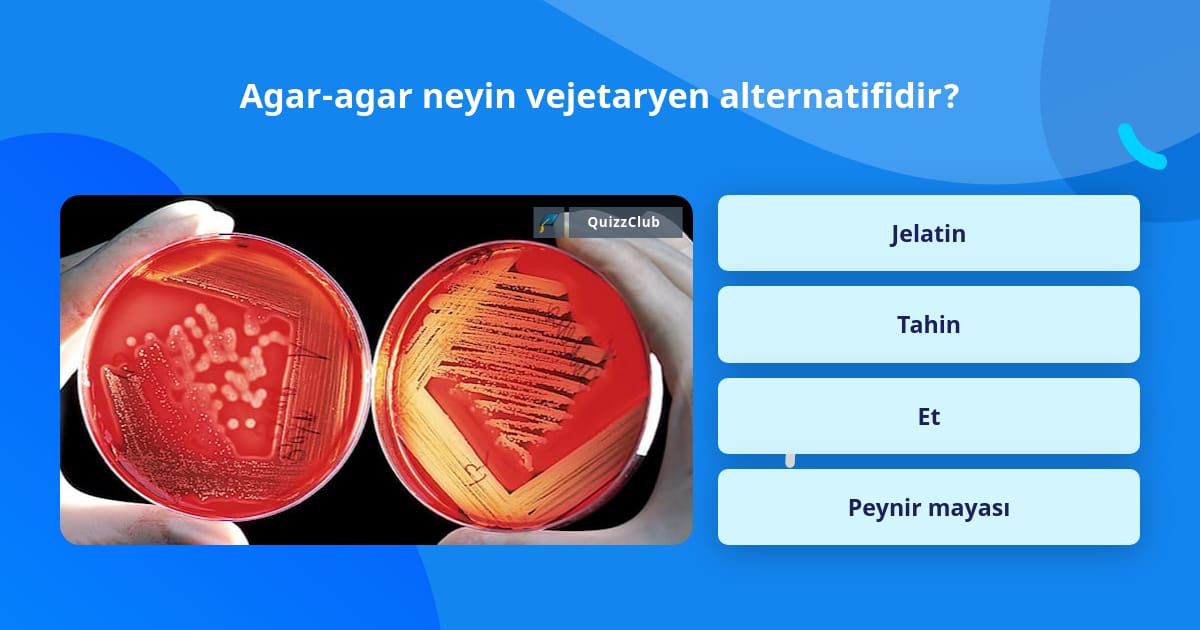

Агар код
Агар код 110 фотографий
Билеты пдд с изменениями 1 апреля 2026
Пульт для ворот каме
Предложение со словом ура существительное
Польза махов руками
Коты подушки связать
Megapack logo
Новый авто череповец
Оспамокс 500 таблетки
Перечислите разноспрягаемые глаголы примеры
Спб работа вакансия разнорабочий